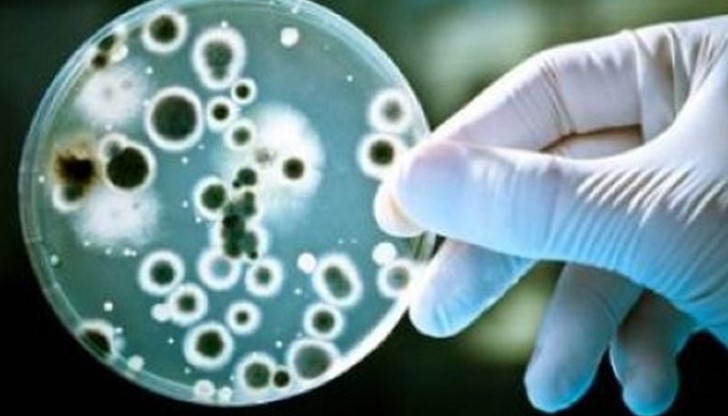

Иде бич по-страшен от рака
- Редактор: Виктор Тошев
- Коментари: 0
Резистентността на бактериите към антибиотиците според микробиолозите ще стане по-опасна от злокачествените заболявания.
По данни на Световната здравна организация 50 на сто от изписваните антибиотици са неправилно предписани. Правилната употреба на антибиотиците е тема, която ще събере в Народното събрание експерти в областта.
Пациентската организация "Заедно с теб" посочва за фокус на дискусията антимикробната резистентност и правилната употреба на антибиотици в България, съобщи БНР.
Всяка година само в САЩ 2 милиона души са засегнати от сериозни инфекции, причинени от бактерии, които са резистентни към един или повече антибиотика, а 23 000 души умират от инфекции, причинени от резистентни бактерии, обяви Пенка Георгиева, организатор на дискусията за правилното използване на антибиотиците у нас.
Повече пациенти ще умират от тези инфекции, отколкото от рак. Времето, в което няма да бъдат правени секцио и химиотерапия, защото няма да можем да се справим, е съвсем близо, каза Георгиева.
Неправомерната и нерегламентирана употреба на антибиотици, включително честото „самопредписване“ от пациентите са най-важните фактори, който водят към резистентност.
Хората си купуват скъпи и широкоспектърни антибиотици, които пият без направена антибиограма, посочва Георгиева. По думите ѝ такова поведение е безотговорно, особено когато нерегламентираното се прилага към деца. Отговорността е поделена между лекари и пациенти, категорична бе тя.
Националният център по заразни и паразитни болести и Асоциацията на микробиолозите контролира антибиотичната резистентност у нас, като събира данни от над 150 лаборатории, засягащи болничното и извънболнично лечение, обясни проф. Тодор Кантарджиев, национален консултант по микробиология.
Анализират се данни за това какви са най-честите причинители на инфекции у нас. Информация за еволюцията на резистентността на най-опасните щамове-причинители на вътрешноболничните инфекции е налична за всички специалисти, които се интересуват, обяви проф. Кантарджиев. Като негатив той посочи занижения интерес на лекарите към организираните курсове по темата за антибиотичната резистентност. Има готова антибиотична стратегия, декларира още националният консултант.
























Ботьо Ботев: Случаят "Петрохан" е без аналог в световната...
Странен хляб изненада клиентка в Русе
ИТН иска пълна забрана за публични функции на...
ИТН иска пълна забрана за публични функции на...
Община Русе подновява процедурата за продажба на общински...